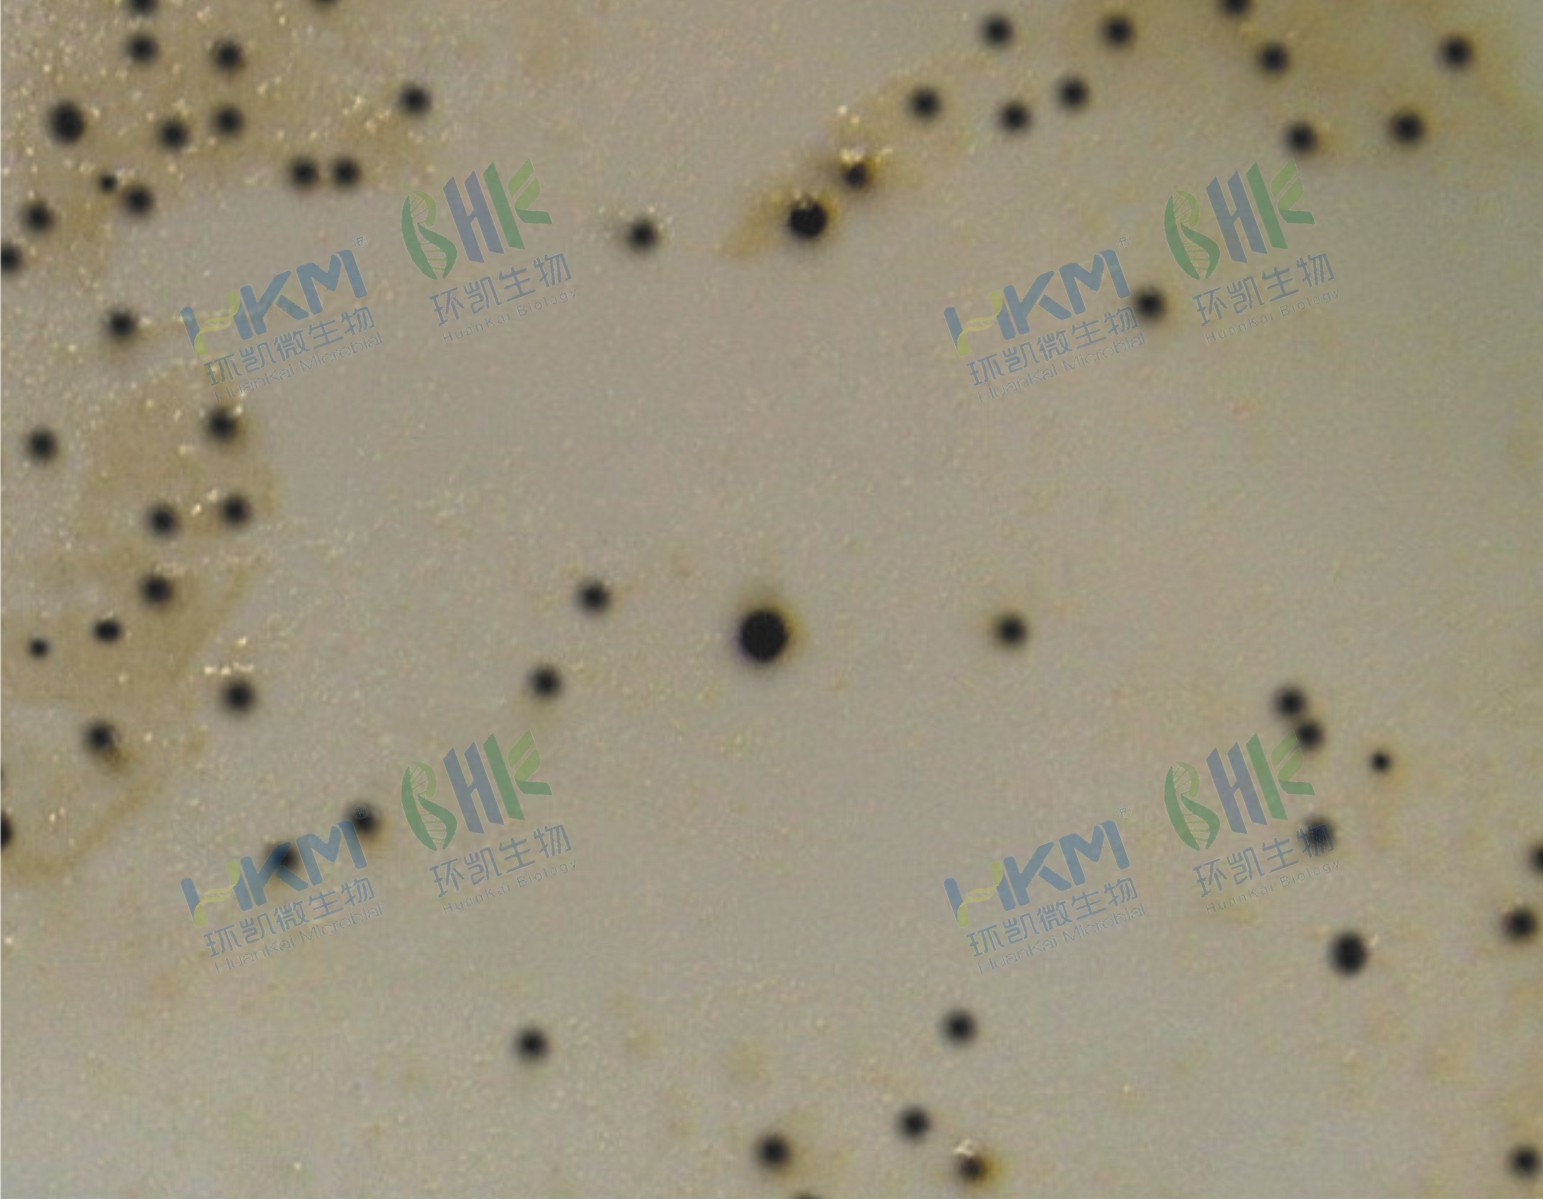

商品詳細
行業(yè)應用
相關論文
說明書
培訓資料
相關視頻
產(chǎn)品名稱:胰蛋白月示-亞硫酸鹽-瓊脂培養(yǎng)基
英文名稱:Tryptose Sulfite Agar
產(chǎn)品編號與包裝規(guī)格:
| 產(chǎn)品編號 | 產(chǎn)品類型 | 包裝規(guī)格 |
|---|---|---|
| 024045 | 干粉 | 250g/瓶 |
產(chǎn)品用途:用于城市供水中濾膜法測定亞硫酸鹽還原厭氧菌(梭狀芽孢桿菌)孢子。
檢驗原理:胰蛋白胨、大豆蛋白胨和酵母膏粉提供碳氮源、維生素和生長因子;焦亞硫酸鈉和檸檬酸鐵銨為硫化氫指示劑;梭狀芽孢桿菌將焦亞硫酸鈉還原為硫化氫,與鐵離子結果形成黑色沉淀。
胰蛋白月示-亞硫酸鹽-瓊脂培養(yǎng)基配方成分:
| 配方(每升) | 含量 |
|---|---|
| 胰蛋白月示 | 15.0g |
| 大豆蛋白胨 | 5.0g |
| 酵母膏粉 | 5.0g |
| 焦亞硫酸鈉(Na2S2O5) | 1.0g |
| 檸檬酸鐵銨 | 1.0g |
| 瓊脂 | 15.0g |
| 最終pH 7.6±0.2 | |
使用方法:稱取本品42g,加入1 L蒸餾水或去離子水,攪拌加熱煮沸至完全溶解,分裝三角瓶,121℃滅菌15分鐘,待冷至50℃左右傾注平皿。
胰蛋白月示-亞硫酸鹽-瓊脂培養(yǎng)基質量控制(下列質控菌株接種后于35~37℃厭氧培養(yǎng)24h,觀察結果如下表:):
| 指標 | 質控菌株及編號 | 標準值 | 特征性反應 |
|---|---|---|---|
| 生長率 | 生孢梭菌CMCC64941 | PR≥0.7 | 黑色菌落 |
| 產(chǎn)氣莢膜梭菌ATCC13124 |
儲存條件與保質期:貯存于避光、干燥處,用后立即旋緊瓶蓋;有效期三年。
參考文獻:CJ/T 141- 2018中華人民共和國城鎮(zhèn)建設行業(yè)標準 城市供水水質檢驗方法
024045 胰蛋白月示-亞硫酸鹽-瓊脂培養(yǎng)基 250g/瓶 相關產(chǎn)品(用于梭狀芽孢桿菌(產(chǎn)氣莢膜、肉毒梭菌)檢驗檢測):
| 產(chǎn)品名稱 | 產(chǎn)品貨號 | 產(chǎn)品類型 | 規(guī)格 | 產(chǎn)品說明及用途 |
| 亞硫酸鐵多粘菌素B培養(yǎng)基基礎 | 028024 | 干粉基礎 | 250g/瓶 | 用于羽絨、羽毛中亞硫酸還原梭狀芽孢桿菌的檢測。(GB/T10288) |
| 亞硫酸鐵多粘菌素B瓊脂添加劑 | SR0430 | 配套試劑 | 10支/盒 | |
| 液體硫乙醇酸鹽培養(yǎng)基(FT) | 028030 | 干粉 | 250g/瓶 | 用于培養(yǎng)需氧菌、微需氧菌和厭氧菌,還用于藥品生物制品的無菌試驗,及食品中產(chǎn)氣莢膜羧菌的厭氧培養(yǎng)。(GB4789.13) |
| 硫乙醇酸鹽流體培養(yǎng)基(FT) | 028033 | 干粉 | 250g/瓶 | 用于培養(yǎng)需氧菌、微需氧菌和厭氧菌,還用于藥品生物制品的無菌試驗。(2020CP) |
| 硫乙醇酸鹽流體培養(yǎng)基(FT) | 028033P1 | 顆粒 | 250g/瓶 | |
| 硫乙醇酸鹽流體培養(yǎng)基(高透明度) | 028034 | 干粉 | 250g/瓶 | 用于培養(yǎng)需氧菌、微需氧菌和厭氧菌,還用于藥品生物制品的無菌試驗。(2020CP) |
| 硫乙醇酸鹽流體培養(yǎng)基(高透明度) | 028034P1 | 顆粒 | 250g/瓶 | |
| 硫乙醇酸鹽流體培養(yǎng)基(FT)(玻璃試管) | CP8033G2 | 管裝成品 | 7.5mL×20支 | 用于培養(yǎng)需氧菌、微需氧菌和厭氧菌,還用于藥品生物制品的無菌試驗。(2020CP) |
| 硫乙醇酸鹽流體培養(yǎng)基(20版藥典) | CP8033P1 | 瓶裝液體成品 | 100mL×6瓶 | |
| 硫乙醇酸鹽流體培養(yǎng)基(20版藥典) | CP8033P2 | 瓶裝液體成品 | 250mL×6瓶 | |
| 硫乙醇酸鹽流體培養(yǎng)基(20版藥典) | CP8033P6 | 瓶裝液體成品 | 205mL×24瓶 | |
| 梭菌增菌培養(yǎng)基 | 027145 | 干粉 | 250g/瓶 | 用于梭菌的增菌培養(yǎng)。(2020CP) |
| 梭菌增菌顆粒培養(yǎng)基 | 027145P1 | 顆粒 | 250g/瓶 | |
| 梭菌增菌培養(yǎng)基 | CP7145P1 | 瓶裝液體成品 | 500mL×15瓶 | |
| 哥倫比亞瓊脂培養(yǎng)基 | 024064 | 干粉 | 250g/瓶 | 用于藥品中梭菌的檢測。(2020CP) |
| 哥倫比亞瓊脂顆粒 | 024064P1 | 顆粒 | 250g/瓶 | |
| 哥倫比亞瓊脂平板(含慶大霉素) | CP4064P1 | 成品平板 | 90mm×20個 | |
| 緩沖-甘油氯化鈉溶液 | 025017 | 干粉 | 250g/瓶 | 用于樣品的保存。(GB 4789.13) |
| 庖肉培養(yǎng)基基礎 | 027140 | 干粉基礎 | 250g/瓶 | 用于厭氧菌的增菌培養(yǎng)和保存,還用于肉毒梭菌及兼性厭氧和厭氧梭狀芽孢桿菌的檢驗。(GB4789.12) |
| 庖肉培養(yǎng)基(玻璃試管) | C27140G1 | 管裝成品 | 15mL×20支 | |
| 庖肉培養(yǎng)基(含鐵粉)(玻璃試管) | C27140G2 | 管裝成品 | 15mL×20支 | |
| 庖肉牛肉粒 | 027150 | 肉粒 | 100g/瓶 | 加入庖肉基礎,配成庖肉培養(yǎng)基。(GB4789.12) |
| 胰胨-亞硫酸鹽-環(huán)絲氨酸瓊脂基礎(TSC) | 028020 | 干粉基礎 | 100g/瓶 | 用于食品和臨床樣本中產(chǎn)氣莢膜梭菌的分離培養(yǎng)和計數(shù)。(GB4789.13) |
| TSC瓊脂平板 | C28020B1 | 成品平板 | 90mm×20個 | |
| 環(huán)絲氨酸(胰胨-亞硫酸鹽-環(huán)絲氨酸培養(yǎng)基配套試劑) | SR0290 | 凍干試劑 | 10支/盒 | |
| 卵黃瓊脂培養(yǎng)基基礎 | 027160 | 干粉基礎 | 250g/瓶 | 用于厭氧梭狀芽孢桿菌的分離培養(yǎng)和卵磷脂酶試驗。(GB8538,GB4789.13) |
| 卵黃瓊脂平板 | C27160B1 | 成品平板 | 90mm×20個 | |
| 50%卵黃液 | 029250 | 配套試劑 | 5mL×10支 | |
| 厭氧卵黃瓊脂基礎 | 027165 | 干粉基礎 | 250g/瓶 | 用于進出口食品中肉毒梭菌的培養(yǎng)。(GB4789.12) |
| 亞硫酸鹽-多粘菌素-磺胺嘧啶(SPS)瓊脂培養(yǎng)基 | 028031 | 干粉 | 250g/瓶 | 用于生活飲用水中產(chǎn)氣莢膜梭菌的分離培養(yǎng)和計數(shù)。(GB/T5750) |
| SPS瓊脂平板 | CP0422 | 成品平板 | 90mm×20個 | |
| 亞硫酸鹽-多粘菌素-磺胺嘧啶瓊脂配套試劑 無色液體 | SR0150 | 配套試劑 | 2×5支 | |
| 亞硫酸鐵瓊脂 | 028023 | 干粉 | 250g/瓶 | 用于食品、飲用水、生產(chǎn)環(huán)境中厭氧亞硫酸鹽還原梭狀芽孢桿菌的分離培養(yǎng)和計數(shù)。(SN/T1071) |
| 動力-硝酸鹽培養(yǎng)基(A法) | 022270 | 干粉 | 250g/瓶 | 用于鑒別細菌動力和硝酸鹽還原試驗。(GB8538,GB4789.13) |
| 緩沖動力-硝酸鹽培養(yǎng)基(B法) | 022272 | 干粉 | 250g/瓶 | |
| 硝酸鹽還原試劑 | 029070 | 配套試劑 | 10mL×2瓶 | |
| 含鐵牛奶培養(yǎng)基 | 028035 | 干粉 | 250g/瓶 | 用于產(chǎn)氣莢膜梭菌的鑒定。(GB8538,GB4789.13) |
| 含鐵牛奶培養(yǎng)基(玻璃試管) | C28035G1 | 管裝成品 | 10mL×20支 | |
| 明膠磷酸鹽緩沖液 | 027143 | 干粉 | 250g/瓶 | 用于食品中肉毒梭菌樣品的稀釋。 |
| 明膠-磷酸鹽緩沖液 | C27143D1 | 袋裝成品 | 30mL×10袋 | |
| 0.1%蛋白胨水 | 028025 | 干粉 | 250g/瓶 | 用于樣品的稀釋。(GB4789.13) |
| 0.1%蛋白胨水 | C28025D4 | 袋裝成品 | 100mL×10袋 | |
| 0.1%蛋白胨水(塑料試管) | C28025G1 | 管裝成品 | 9mL×20支 | |
| 胰蛋白胨葡萄糖酵母浸膏肉湯基礎(TPGYT肉湯基礎) | 027147 | 干粉基礎 | 250g/瓶 | 用于進出口食品中肉毒梭菌的增菌培養(yǎng)。(GB4789.12) |
| TPGYT肉湯試管 | C27147G1 | 管裝成品 | 15mL×20支 | |
| 乳糖明膠 | 075850 | 生化管 | 20支/盒 | 用于產(chǎn)氣莢膜梭菌的驗證試驗(GB 4789.13-2012)。 |
| 產(chǎn)氣莢膜梭菌核酸檢測試劑盒(PCR-熒光探針法) | FZ003BF2 | 分子試劑盒 | 48test | 用于食品和水體中產(chǎn)氣莢膜梭菌的定性檢測。 |
| 肉毒梭菌A/B型毒素基因PCR檢測試劑盒 | KJD06P | 分子試劑盒 | 24test | 用于食品中肉毒梭菌A/B型毒素基因的檢測。 |
| 肉毒梭菌E/F型毒素基因PCR檢測試劑盒 | KJD07P | 分子試劑盒 | 24test | 用于食品中肉毒梭菌E/F型毒素基因的檢測。 |
